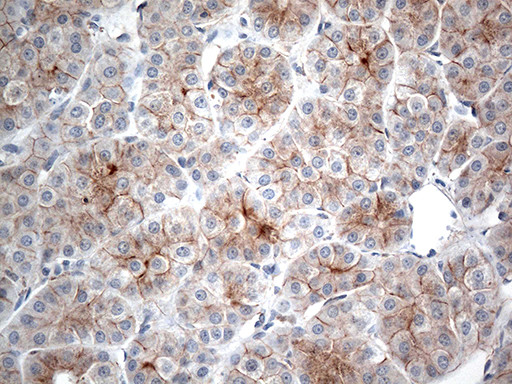
IFNLR1 Antibody in Immunohistochemistry (Paraffin) (IHC (P))

Search
OriGene
IFNLR1 Monoclonal Antibody (OTI3F5), TrueMAB™
{{$productOrderCtrl.translations['antibody.pdp.commerceCard.promotion.promotions']}}
{{$productOrderCtrl.translations['antibody.pdp.commerceCard.promotion.viewpromo']}}
{{$productOrderCtrl.translations['antibody.pdp.commerceCard.promotion.promocode']}}: {{promo.promoCode}} {{promo.promoTitle}} {{promo.promoDescription}}. {{$productOrderCtrl.translations['antibody.pdp.commerceCard.promotion.learnmore']}}
产品信息
TA812609
种属反应
宿主/亚型
分类
类型
克隆号
抗原
偶联物
形式
浓度
规格
纯化类型
保存液
内含物
保存条件
运输条件
靶标信息
The protein encoded by this gene belongs to the class II cytokine receptor family. This protein forms a receptor complex with interleukine 10 receptor, beta (IL10RB). The receptor complex has been shown to interact with three closely related cytokines, including interleukin 28A (IL28A), interleukin 28B (IL28B), and interleukin 29 (IL29). The expression of all three cytokines can be induced by viral infection. The cells overexpressing this protein have been found to have enhanced responses to IL28A and IL29, but decreased response to IL28B. Three alternatively spliced transcript variants encoding distinct isoforms have been reported.
仅用于科研。不用于诊断过程。未经明确授权不得转售。
篇参考文献 (0)
生物信息学
蛋白别名: class II cytokine receptor CRF2/12; CRF2-12; Cytokine receptor class-II member 12; Cytokine receptor family 2 member 12; IFN-lambda receptor 1; IFN-lambda-R1; IL-28 receptor subunit alpha; IL-28R-alpha; IL-28RA; Interferon lambda receptor 1; interleukin 28 alpha receptor; interleukin 28 receptor A; interleukin 28 receptor, alpha (interferon, lambda receptor); interleukin or cytokine receptor 2; Interleukin-28; Interleukin-28 receptor subunit alpha; LICR2; Likely interleukin or cytokine receptor 2
基因别名: CRF2/12; IFNLR; IFNLR1; IL-28R1; IL28RA; LICR2
UniProt ID: (Human) Q8IU57
Entrez Gene ID: (Human) 163702